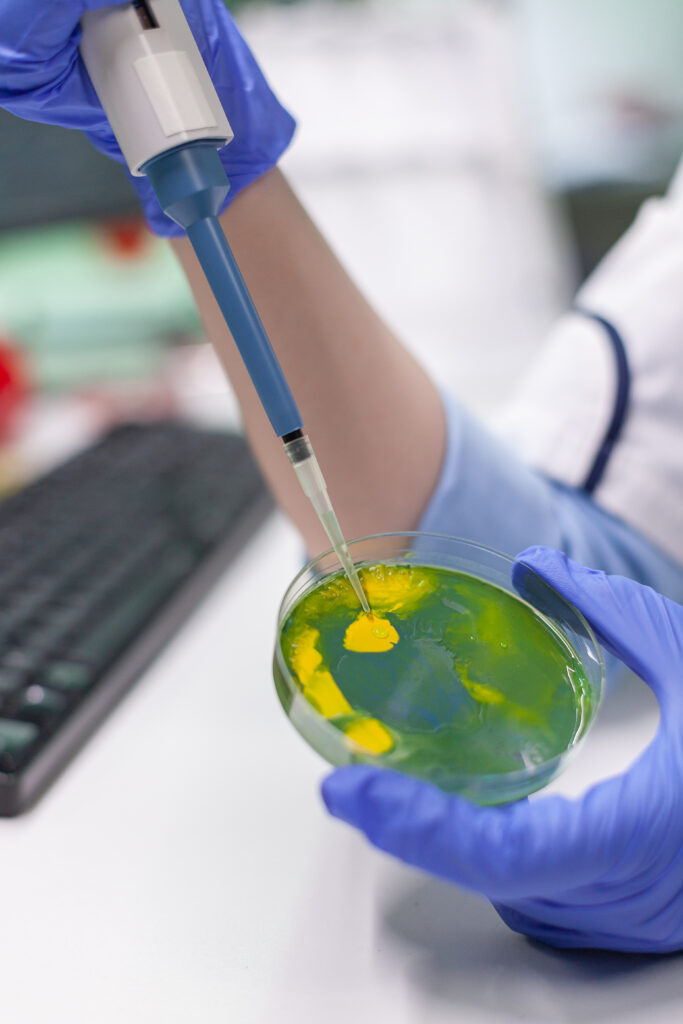

.. SUNNY transparency, and the power of nature ..
Ethics in a Bottle. Our Story.
A family-owned company driven by a return to integrity
With Purpose and Guided by Nature
We are two siblings driven by the same vision: to elevate the nutraceutical industry standard by returning to the essentials. Our journey began with a question as simple as it was powerful: Why should wellness compromise ethics? After years of witnessing shortcuts, dubious ingredients, and profit-driven formulas, we knew we had to build a better path.
Sunny Nutraceuticals was born with the mission to create the highest quality supplements, ethically crafted with clean and traceable ingredients.
Mission, Vision, and Values
Our Foundational Pillars
At Sunny Nutraceuticals, we don't just make supplements; we set the standard for how they should be made. Our vision and mission are the roadmap that guides every decision, ensuring that science, ethics, and nature work in perfect harmony for the well-being of our customers and the planet.
vision

To become a global benchmark in nutraceutical wellness, where science, ethics, and nature converge to empower every person to live a healthier, more conscious life.
mission

To elaborate high-quality supplements with clean, ethically sourced ingredients, supporting true health through transparent processes and a firm commitment to the well-being of people and the planet.
Values

Integrity, Transparency, Sustainability, Innovation, Empathy, Excellence.
Facilities and Standards
- Excellence in Denver, Colorado
Every formula is born in our modern facilities designed under the highest industry standards, aligned with GMP and FDA guidelines. We feature advanced equipment for crafting capsules, gummies, powders, and more. Each stage is supervised by specialized technicians, with strict quality control protocols. We work with external laboratories for independent testing, reinforcing our transparency.
Commitment to Innovation
- Science at the Service of Health
Innovation is not a complement; it is our foundation. We explore the connection between science and nature to develop effective, clean, and intelligent supplements. Our R&D approach combines evidence-based formulations with the latest trends in functional nutrition. True progress is measured not just by what is new, but by what truly works.

